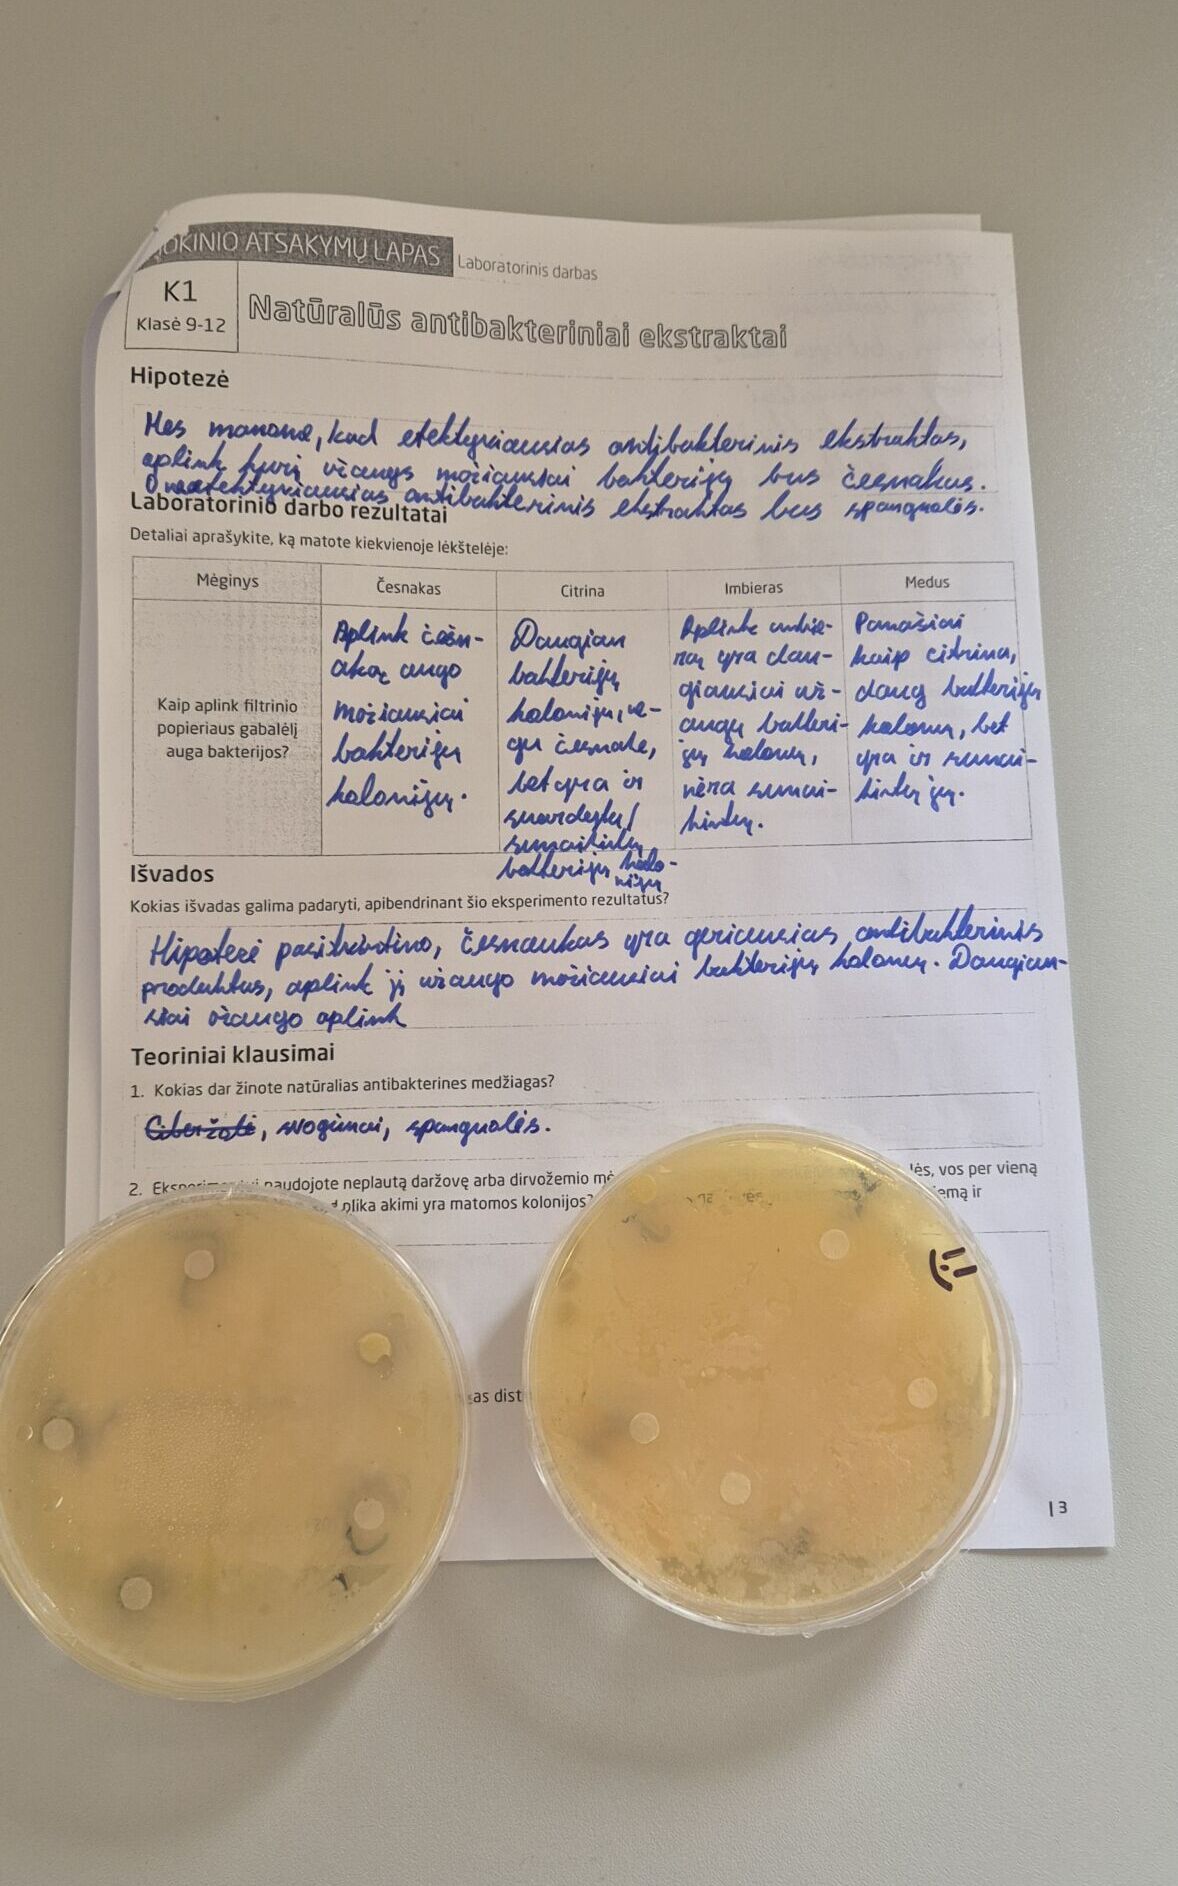

Kovo–balandžio mėn. tradiciškai gimnazijoje organizuota Gamtos mokslų savaitė – vyko praktinės ir tiriamosios veiklos. Mokiniai gilino gamtamokslines žinias ir ugdėsi tyrimo įgūdžius.
II kl. mokiniai fizikos pamokose atliko praktinį darbą „Šviesos lūžio tyrimas“ – nagrinėjo šviesos spindulio krypties kitimą skirtingose terpėse. III kl. mokiniai STEAM centre, minėdami tarptautinę biofizikos savaitę, naudodami CO₂ sensorius, tyrė fotosintezės intensyvumą. Biologijos pamokose mokiniai vykdė praktinį darbą „Modifikacinio kintamumo tyrimas“, analizavo aplinkos veiksnių įtaką organizmų požymiams. Taip pat atliko biotechnologijų praktinį darbą „Antibakterinių ekstraktų tyrimas“ – vertino natūralių medžiagų poveikį mikroorganizmams.
Balandžio 7 d. II kl. mokiniai dalyvavo edukacinėje paskaitoje „Ką žinai apie vandentiekio vandenį? Atrask tvarų požiūrį“, kurią vedė „Šiaulių vandenų“ atstovė Džiuljeta Korsakienė. Paskaitoje aptarti vandens kokybės, tiekimo ir tvaraus vartojimo aspektai.
Šios veiklos skatino mokinių praktinius gebėjimus, kritinį mąstymą ir domėjimąsi gamtos mokslais.
Gamtos mokslų mokytojai